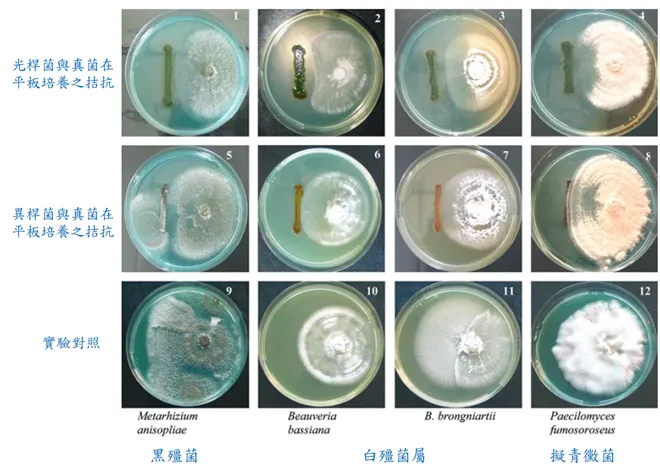
vocus｜新世代的創作平台

光桿菌(Photorhabdus luminescens)屬於腸內桿菌科(Enterobacteriaceae),為革蘭氏陰性,可發出生物光(Bioluminescent)之桿狀細菌,與異小桿線蟲(Heterorhabditis spp.)共生。光桿菌可分泌多種二次代謝產物和水解酵素,包含脂肪酶(lipases)、蛋白酶(protease)、幾丁質分解酵素(chitinase)、蛋白酵素抑制劑(protease inhibitor)、抗生物質(antibiotics)、脂多醣(lipopolysaccharides)、溶血素(hemolysins)和一些高分子量的毒素複合物(high-molecular-weight toxin complexes,Tc),具有殺害昆蟲及病原菌之雙效作用。
斯氏線蟲(Steinernema spp.)與異小桿線蟲(Heterorhabditis spp.)均為昆蟲病原線蟲。異桿菌(Xenorhabdus spp.)與斯氏線蟲(Steinernema spp.)共生,光桿菌則(Photorhabdus luminescens)與異小桿線蟲(Heterorhabditis spp.)共生。
光桿菌有兩種型態,第一種型態是從侵染期間的線蟲中分離出來,稱為I型菌(primary-phase)或初生型菌。在共生菌離開培養的穩定期或用人工飼料培養線蟲的期間,會自然地產生第二種類型,稱為II型菌(secondary-phase)或次生型菌(Akhurst, 1982)。光桿菌I、II型的特性不同,第二型為非黏液樣的菌落形成、不會產生生物光、吸收染料能力喪失,色素、抗生素、蛋白酶與晶體包含體產生的數量明顯減少(Forst et al., 1996;Givaudan et al., 1995, Nealson et al., 1990;Schmidt et al., 1988)
目前光桿菌的抗生物質已知約有五類,在in vitro培養的情況下,經由ethyl acetate萃取下被分離出來鑑定,例如芪衍生物(stilbene derivatives)、蒽醌衍生物(anthraquinone derivatives)、染料木素(genistein)、夫喃衍生物(furan derivatives)、酚衍生物(phenol derivatives)(Hu et al.,1997,Li et al.,1995b:Paul et al.,1981,Sztaricskai et al.,1992)。其中芪衍生物已有兩種抗生素經由in vitro and in vivo的光桿菌中被鑑定分離出來。3,5-dihydroxy-4-isopropylstilbene (ST) 和3,5-dihydroxy-ethylstilbene。可抑制部分細菌、真菌及植物線蟲。
本篇文章將著重在光桿菌對於抗病原菌部分加以說明,並列舉國外文獻應用實例加以敘述;
光桿菌(P. luminescens)文獻報告
在針對害蟲的研究中,協同性相互作用已經從昆蟲病原線蟲的某些組合中觀察到與其他病原體的存在。然而,昆蟲病原菌之間的相互作用、線蟲和其他昆蟲病原體也可能具有拮抗作用。如果為了得到更好控制害蟲的生物方式,想將昆蟲病原線蟲與真菌結合,應該意識到生物防治劑之間可能的相互作用。此研究測試目的鑑於聯合昆蟲病原線蟲和真菌在防治中的應用,須確定兩者之間的拮抗作用;如共生細菌
X. poinarii 和 P. luminescens 以及一些昆蟲病原真菌,如M. anisopliae, Paecilomyces fumosoroseus,B. bassiana 和 B. brongniartii。
上述平板培養基之實驗結果,得知異桿菌相較於光桿菌應無較強勢之代謝物拮抗其昆蟲病原真菌。然而,光桿菌對這些昆蟲病原真菌有較強之拮抗,顯示其代謝物可能會減少其昆蟲病原菌的結合,因此僅可以高濃度控制昆蟲。然而若以昆蟲病原線蟲(含光桿菌或異桿菌寄生)及這些昆蟲病原菌相結合應用應可以有效地控制其幼蟲,增加其死亡率。結合線蟲和真菌以提高昆蟲控制的功效,對昆蟲的高傳染性以及相對於真菌的顯著不同的作用方式,可以相對地減少菌種間拮抗作用,表明這種方法具有很大的潛力應用於控制蟲害。
光桿菌(P. luminescens)文獻報告
應用實例
※應用於果實保存(荔枝)
參照文獻報告(Duo Lai et al. 2020)。
荔枝果皮褐變,長期以來一直被認為是主要的收穫後限制因素,主要因素是由於紅色素的降解、果皮酚類物質的氧化和活性氧 (ROS) 的作用。目前,合成殺菌劑、化學防腐劑和二氧化硫 (SO2) 燻蒸是延緩果實腐爛和延長果實保存時間最普遍的方法。然而濫用化學品引起了越來越多對於人類健康和環境污染的潛在風險的關注。
拮抗微生物,如芽孢桿菌枯草芽孢桿菌和植物乳桿菌,已被報導具有潛力作為荔枝果實採後之腐爛防治劑。部分天然微生物代謝產物,如降血黴素(hypothemycin)或玉米胺(zeamines)的應用以及部分胞外酵素,如苯丙胺酸降解酶(phenylalanine ammonia lyase)、幾丁質酶(chitinase)、β-1, 3-葡聚醣酶(β-1, 3-glucandase)等也被證明對荔枝保存有很好的抗真菌活性,防治採收後病害,顯著減少果實腐爛,延長荔枝採收後的貯藏時間。
本篇文獻內容為;利用光桿菌之培養液測試荔枝保存時間之變化,並測試果實衰變相關之數據加以佐證。
本文獻報告中之試驗概要;
將採收後的荔枝浸泡在光桿菌稀釋液(濃度1 x 108/ml)中五分鐘,再裝進聚乙烯薄膜袋中,放進25℃、濕度40-50%的培養箱中存放7天。存放期間於1、3、5、7天取出部分果實,測定相關數值及觀察果實外觀變化。
以下將列舉此篇文獻報告中之實驗數據說明。


透過上圖數據及荔枝外觀圖片;未浸泡光桿菌稀釋液之荔枝,於第5天開始外觀出現些微褐色,第7天開始腐爛及發黴。然而,浸泡光桿菌稀釋液之荔枝在第5天外觀上仍呈現鮮紅色,第7天也仍未有發黴及腐爛現象。數據顯示;在實驗期7天時間裡,浸泡過光桿菌稀釋液之荔枝果實,與未處理之荔枝果實比較,其褐變指數及衰敗率均較低。
綜合實驗數據報告說明:
該研究後續尚測試許多抗氧化能力及氧化程度等數據,數據報告表明;用光桿菌進行荔枝採後處理能有效延緩果皮褐變,減少自然腐爛和鮮果重量減輕,保持較高的總可溶性固形物(TSS)、可低定酸(TA)含量以及荔枝果肉中的總可溶性糖和維生素C含量。光桿菌經由增加海藻糖積累達到抑制果實腐爛、增強防禦酶(抗氧化酵素)活性;包括過氧化物酶(POD)、超氧化物歧化酶(SOD)和過氧化氫酶(CAT)(增強這些酵素可以使果實的抗氧化能力增加,達到減少氧化造成的衰敗),並抑制荔枝果實中活性氧化物(ROS)、丙二醛(MDA)和過氧化氫(H2O2)的增加(抑制這些氧化物可以有效減緩果實因氧化而加速衰敗)。
參考文獻
- 線蟲共生細菌光桿菌之開發。(高穗生、謝奉家)。
- Antagonism between entomopathogenic fungi and bacterial symbionts of entomopathogenic nematodes. BioControl (2005) 50: 465–475 ( Maurice MOENS et al., 2005)
- Suppression of fruit decay and maintenance of storage quality of litchi by Photorhabdus luminescens Hb1029 treatment. Scientia Horticulturae 259 (2020) ( Shizi Kua et al.,2020).
※為使國內參閱者方便閱讀,本篇文章分享之國外文獻報告數據均已經自行翻譯為中文,原文部分均為英文。




















